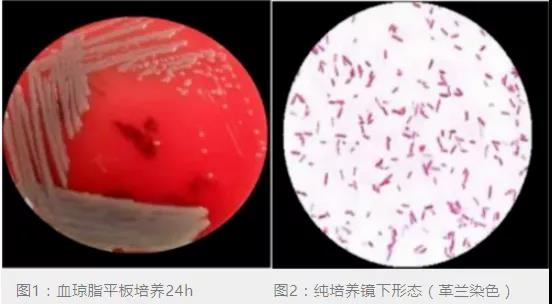

查看更多
密码过期或已经不安全,请修改密码
修改密码
壹生身份认证协议书
同意
拒绝
同意
拒绝
同意
不同意并跳过

1岁10月男婴,病史3月余,双侧人工耳蜗植入术后出现发热、呕吐、抽搐,外院查脑脊液细胞数最高至2303×10^6/L,多核细胞为主,葡萄糖含量低、蛋白高,脑脊液培养“肺炎链球菌”,诊断肺炎链球菌中枢神经系统感染。给予美罗培南、万古霉素等药物治疗后体温恢复正常,脑脊液指标明显好转。后因脑积水行脑室外引流术,术后数天患儿再次出现发热,脑脊液细胞数最高至853×10^6/L,多核细胞为主,葡萄糖含量低、蛋白高,先后给予美罗培南、万古霉素、利奈唑胺等药物治疗后感染控制不佳,脑脊液细菌培养提示“嗜麦芽窄食单胞菌”。故诊断嗜麦芽窄食单胞菌中枢神经系统感染。

嗜麦芽窄食单胞菌(Stenotrophomonas maltophilia)是一种普遍存在的、需氧的、非发酵的革兰氏阴性条件致病菌。该菌感染通常为医院获得性感染,即使为社区获得,患者大多时常就医或存在易感因素。最常见的感染类型为肺炎和菌血症,肺炎最常发生于机械通气患者,菌血症患者最常发生于导管相关感染。中枢神经系统感染较少见。因该菌对多种抗菌药物固有耐药,治疗困难,脑膜炎总体死亡率约为17%。

嗜麦芽窄食单胞菌对碳青霉烯类抗生素天然耐药,对青霉素、头孢菌素、氨基糖苷类抗生素耐药率高,对于左氧氟沙星、米诺环素、复方新诺明的耐药较低,但近年来有报道显示对复方新诺明的耐药率明显上升,存在较大的地区差异。
主要耐药机制有:(1)可产生L1和L2两种β-内酰胺酶,水解大多数的β-内酰胺类抗生素,两种酶的表达受AmpR基因调节,产生不同程度的耐药性。(2)可分泌和释放氨基糖苷类修饰酶,影响氨基糖苷类抗生素与细菌靶位的亲和力,从而失去抗菌活性。(3)编码DNA解旋酶和拓扑异构酶IV的基因突变导致喹诺酮类药物耐药。(4)复方新诺明耐药与I类整合子的sul基因和插入元件ISCR相关的sul2基因介导有关。(5)还可编码多种外排泵介导β-内酰胺类、氨基糖苷类、四环素、氯霉素和喹诺酮类抗生素耐药。(6)可形成生物被膜黏附于医用材料,也可黏附于组织细胞上,长期定植于体内,有利于耐药的形成,并导致慢性感染反复发作。


嗜麦芽窄食单胞菌引起的中枢神经系统感染目前文献报道仅35余例,儿童组病例11例。35例中枢神经系统感染病例中,25例患者在起病前接受神经外科干预,其中21例置入了引流装置(主要是脑室外引流和VP分流),3例接受了开颅手术,1例接受了神经内镜操作。嗜麦芽窄食单胞菌中枢神经系统感染临床表现缺乏特异性,常表现为发热和神经功能障碍,包括意识水平改变、深反射消失和偏瘫等。颅内压增高症状明显。脑脊液改变与化脓性脑膜炎相似,表现为白细胞升高,以多个核细胞增加为主,蛋白含量增高,葡萄糖含量降低。符合规范采集的脑脊液涂片或脑脊液培养出嗜麦芽窄食单胞菌具有诊断意义,引流装置采集的引流液培养需结合临床实际分析。本例患儿脑室外引流手术后数天再次出现发热,同期脑脊液白细胞再次升高,糖含量减低,蛋白含量升高,侧脑室引流液及经腰穿脑脊液均培养出嗜麦芽窄食单胞菌,故嗜麦芽窄食单胞菌中枢神经系统感染诊断明确。

对存在高危因素的患者,要警惕该菌感染的发生,延误治疗可导致很高死亡率。仔细评估分离出的菌代表真性感染还是定植,对于感染病例应立即用抗生素治疗,不恰当地使用抗生素将导致不良反应增加。
嗜麦芽窄食单胞菌中枢神经系统感染的病例较少,尚无明确推荐的抗感染治疗方案,根据文献显示,若经脑脊液培养证实为嗜麦芽窄食单胞菌感染,经验性治疗需要包含复方新诺明(根据肾功能调整剂量),然后根据药敏结果和治疗效果调整用药。
文献报道的治疗方案中,联合治疗方案通常以复方新诺明为基础,联合其他抗菌药物如抗假单胞菌头孢菌素(头孢他啶)、氟喹诺酮(环丙沙星、左氧氟沙星、莫西沙星)等。有装置感染,同时还需要将感染的装置移除。本例患儿治疗方案为复方新诺明联合头孢他啶治疗,并移除感染装置,患儿体温恢复,脑脊液指标明显好转,脑脊液培养转为阴性。
文献报道嗜麦芽窄食单胞菌中枢神经系统感染的治疗疗程至少为2周,多为3-4周,甚至更长时间。

泛耐药(extensively-drug resistant,XDR)嗜麦芽窄食单胞菌中国专家共识推荐治疗方案

在免疫功能严重受损或日常活动能力严重衰弱者中,嗜麦芽窄食单胞菌感染可引起严重病况和高死亡率。因此尽可能降低嗜麦芽窄食单胞菌感染发病率、减少耐药菌株的出现十分重要。包括:合理使用抗生素,避免长期或不必要地使用器械或设备,以及遵守手卫生习惯。

作者 北京儿童医院感染内科 祁洪、李勤静
本文首发自BCH儿童感染
查看更多